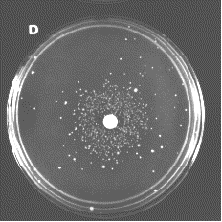

Ames Test
A test for determining if a chemical is a mutagen. Named for its developer, Bruce Ames.
The use of the Ames test is based on the assumption that any substance that is mutagenic (for the bacteria used in his test) may also turn out to be a carcinogen; that is, to cause cancer. Although, in fact, some substances that cause cancer in laboratory animals (dioxin, for example) do not give a positive Ames test (and vice-versa), the ease and low cost of the test make it invaluable for screening substances in our environment for possible carcinogenicity.
The bacterium used in the test is a strain of Salmonella typhimurium that caries a defective (mutant) gene making it unable to synthesize the amino acid histidine (His) from the ingredients in its culture medium. However, some types of mutations (including this one) can be reversed, a back mutation, with the gene regaining its function. These revertants are able to grow on a medium lacking histidine.
 The picture (courtesy of Bruce Ames) shows a qualitative version of the Ames test. A suspension of a histidine-requiring (His-) strain of Salmonella typhimurium has been plated with a mixture of rat liver enzymes on agar lacking histidine. The disk of filter paper has been impregnated with 10µg of 2-aminofluorine, a known carcinogen. The mutagenic effect of the chemical has caused many bacteria to regain the ability to grow without histidine, forming the colonies seen around the disk. The scattered colonies near the margin of the disk represent spontaneous revertants.
The picture (courtesy of Bruce Ames) shows a qualitative version of the Ames test. A suspension of a histidine-requiring (His-) strain of Salmonella typhimurium has been plated with a mixture of rat liver enzymes on agar lacking histidine. The disk of filter paper has been impregnated with 10µg of 2-aminofluorine, a known carcinogen. The mutagenic effect of the chemical has caused many bacteria to regain the ability to grow without histidine, forming the colonies seen around the disk. The scattered colonies near the margin of the disk represent spontaneous revertants.
Many chemicals are not mutagenic (or carcinogenic) in themselves, but become converted into mutagens (and carcinogens) as they are metabolized by the body. This is the reason the Ames test includes a mixture of liver enzymes.
A large number of chemicals used in agriculture and industry give a positive Ames test. Examples are ethylene dibromide (EDB), which is added to leaded gasoline (to vaporize lead deposits in the engine and send them out the exhaust), and ziram, which is used to prevent fungus disease on crops. Some drugs, such as isoniazid (used to prevent tuberculosis) are mutagenic in this test.
The potency of AF-2, a food additive once widely-used in Japan, and safrole, a flavoring agent that used to be added to root beers, caused them to be banned. Saccharin, suspected by some of being a carcinogen, does not give a positive Ames test.
Although most testing has been done on products of the chemical industry, many naturally-occurring substances (like safrole) have been shown to be mutagenic. These include aflatoxin, produced in moldy grain and peanuts (and present in peanut butter at an average level of 2 parts per billion, PPB. Traces of nine different substances that give positive Ames tests have been found in fried hamburger.
Salmonella typhimurium is a prokaryote and thus not a perfect model of the human body (which is why liver enzymes are added to the test). Rapid in vitro tests modeled on the Ames test have been adapted for some eukaryotic cells such as yeast and mammalian cells grown in culture. And thanks to recombinant DNA technology, it is now possible to combine the advantages of rapid in vitro tests like the Ames test with the more realistic conditions of long-term studies in whole animals.
Read more about it in Mutation Testing in Mice.
28 September 1999
The picture (courtesy of Bruce Ames) shows a qualitative version of the Ames test. A suspension of a histidine-requiring (His-) strain of Salmonella typhimurium has been plated with a mixture of rat liver enzymes on agar lacking histidine. The disk of filter paper has been impregnated with 10µg of 2-aminofluorine, a known carcinogen. The mutagenic effect of the chemical has caused many bacteria to regain the ability to grow without histidine, forming the colonies seen around the disk. The scattered colonies near the margin of the disk represent spontaneous revertants.
The picture (courtesy of Bruce Ames) shows a qualitative version of the Ames test. A suspension of a histidine-requiring (His-) strain of Salmonella typhimurium has been plated with a mixture of rat liver enzymes on agar lacking histidine. The disk of filter paper has been impregnated with 10µg of 2-aminofluorine, a known carcinogen. The mutagenic effect of the chemical has caused many bacteria to regain the ability to grow without histidine, forming the colonies seen around the disk. The scattered colonies near the margin of the disk represent spontaneous revertants.